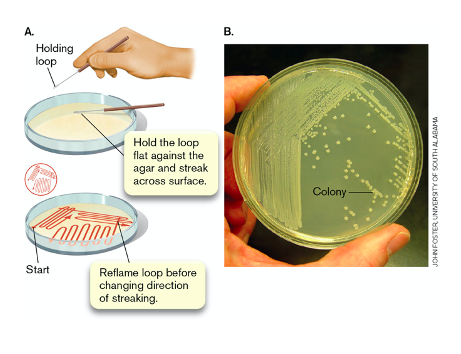

What do all living things need to grow?
sources of carbon and energy
- over eons bacteria has evolved
- ingenious strategies to find, acquire, and metabolize a wide assortment of food sources.
- This owes to the remarkable plasticity of microbial genomes.
what allows us to control the growth of bacteria
- Understanding how bacteria use food to increase cell mass and, ultimately, cell number
- allows us to manipulate them to make useful products (find optimal conditions and nutrients
note: growth = inc in both cell mass (biomass need biochemical techniques to measure) and cell numbers

- microbes evolved to grow in diff environments so they have diff nutritional requirements dependent on ecological niche
- not every microbe sues every element
what are the essential nutrients that must be supplied by the environemnt for microbes
Macronutrients need mg to g quantities
- Major elements in cell macromolecules: C, O, H, N, P, S (remember)
- Cations necessary for protein function: Mg2+, Ca2+, Fe2+, K+
- protein folding or catalysis
Micronutrients (mg to microgram quantities some nanogram)
- trace elements required for enzyme function: Co, Cu, Mn, Zn
*when want to grow bacteria need to supply these, and consider in what form they use it, do they derive carbon from other organic molecules? do they fix CO2?
How do microbes get carbon to build biomass
All earths life forms are based on carbon which they squire diff ways
- autotrophs (primary producers, make inorganic carbon available for other organisms)
- fix CO2 and assemble into organic molecules (mainly sugars)
- ex: assimilation/fixing CO2, and inorganic C-source
- plants, algae, autotrophic bacteria
Heterotrophs
- use organic molecules made by autotrophs, use to make their own biomolecules and generate energy
How do mirobes obtain energy
- all organisms require an energy source
phototrophs obtain energy from chemical reactions triggered by light
- make ATP
Chemotrophs obtain energy from ox-red rxns
- energy generation involves transfer of electrons from e- donor to e- acceptor with release of energy (respiration involved, ETC)
- chemolithotrophs use inorganic mol as a source of electrons
- only found in bacteria
- chemoorganotrophs obtain electrons from organic molecules
what is the role of nitrogen in life
- N2 makes up approx 79% of eather atmosphere but unavailable for use by most organisms
- bacteria play key role in global nitrogen cycle
- nitrogen fixers (Diazotrophs) possess nitrogenase enzyme which converts N2 to ammonium ions NH4+
- only a few bacteria can fix N2, ex = Rhizobium, root endosymbionts of leguminous plants

what is the most basic consideration when trying to culture an organism
- How the cell generates energy: Phototrophy or Lithotrophy
- The form of Carbon utilized by the cell: Heterotrophy or autotrophy
(many autotrophs inhibited by the presence of organic molecules)
- The form of nitrogen used: Diazotrophy
*figure compares heterotrophs and autotrophs

what conditions and considerations are required for measuign growth in the lab
- optimal nutritional and environmental conditions
*assumes good understanding of the growth requirements (nutritional energy, physical, chemical)
Note: less than 1% of organisms can be grown in pure culture, so instead grow mixed populations (real life they exist in complex multispecies communities)
- consider best case scenario (bioremediation agents, microbial production of drugs, enzymes, recombinant proteins)
- consider the worst case scenario (pathogens, food spoiling agents, biofouling)
what are teh different types of bacterial culture media
Complex / rich media are nutrient rich; the exact chemical composition is poorly defined. proves macteria with all chem that were in the previous species
- E.g. contain extracts and ‘enzymatic digests’ of yeast cell, plant and animal tissues;
Minimal defined media contain only those nutrients that are essential for growth of a given microbe.
- Exact components, their concentrations and chemical compositions are known
Enriched media are complex media to which specific growth factors or organic components are added; the bacterium is not capable of making them but needs them to grow.
- E.g. blood proteins, nucleotides, vitamins etc.,
Selective media favor the growth of one organism over another.
- E.g. high or low pH, plus antimicrobials, specific compounds or nutrients (cellulose, benzene)
- checking to see if the bacteria has capacity to grow under these condition
Differential media exploit biochemical/physiological differences between two species that grow equally well (in the medium)
- E.g. contain a pH dye that changes in colour when bacteria produce acidic or alkaline byproducts; differente bacteria based on their metabolic products/activities
how do microbes grow
- e. coli requires rich media and thrive but struggle in situation where nutrients are scarce
- bacteria in most soil and water ecosystem are oligotrophs
*have optimal rate of growth at extreamly low nutrient conc, would die in rich media
- how oligotrophs thrive under extreamely low nutrient conditions remains a mystery
what are the two main forms of culture media
- Liquid or borth: cells gow in suspension
- maximize the number of cells, then centrifuge it to get biomass of cells and then cell free media with all products secreted by the cells
- allows you to study growth characteristics of pur culture
- Solid: usually gelled with agar
* growth in colony forming units (CFU), express number of bacteria in terms of CFU (each colony assumed to be from 1 bacteria)
applications: trying to separate bacteria in samples, isolation of a pure culture, studying diversity in a sample, specific traits (ex: morphologies, physiology, growth, genetics, antibiotic production etc)
what are the main techinques for isolating pure culture
- dilution streaking and spread plating
- allow to obtain well isolated single colonies which can be used to establish pure colonies
assume that one cell = one colony (false assumtion bc some bacteria live/occur in pairs or multiples and cannot be sep by these tehcniques)
describe dilution streaking
- use a loop, pick up tiny amount of sample (loop is calibrated for this)
- drag the loop across the surface on agar plate
- flame loop to sterilize/kill bacteria
- let cool
- touch end of loop on last streak picking up some bacteria and repeat streaking
results: filution of sample with each streaking set increases the probabiltiy of obtaining separation of single bacterium
describe spread plates
- set up ten fold serial dilutions in liquid culture medium
- a small amount of each dilution is then plated onto agar
goal: obtain a dilution that gives nicely separated colonies, select plates woth 30-300 colony forming units - calculate numbers of bacteria in original sample
what percent of prokaryotes are uncultured
>99%
- many species have adapted so well to natural habitates that still do not know how to grow in the lab
- some of these uncultured organisms depend on factors provided by other species that cohabit their niche
- others evolved to live inside other cells (intracellular parasites)
- pthers are obligately symbiotic and cannot grow/survive separated from partners
how do most bacteria devide
- binart fission where a parents increases in size/volume and biomass then splits into two equal daughter cells
*pop doubles after each generation time
*chromosomes replicated as well
- note some cells have mother cell producing progeny that are smaller
- the time it takes for 1 cell to double in size and produce progeny = generation time
-

What is generation time
- in a favourable env with unlimited appropriate resouces and environmental conditions bacteria divide at a constant internal (ie generation time or doubling time)
- generatim time is the time it takes for the population to double
for cells undergoing binary fission: Nt = N0 x 2n
where Nt is final cell number
N0 is original cell number
n is number of generations
what is the bacteria with the fastest generation time? what is the abcteria with the slowest generation time?
fastest = clostridium perfringes (10 min)
slowest - mycobacterium leprae (14 days)
what is batch culture
- volume of liquid emdium within a closed sytem
0 media and nutrients not refreshed
- growth in batch culture is the simplest way to model the effects of changing environemnt of growth on population culture
4 phases: lag, exponential/logarithmic, stationary, death
- changing conditions in system greatly affects bacterial physciology and growth
- nutrients gradually used up and toxic waste gradually builds
- shows ability of bacteria to adapt to chainging env
describe the lag phase
- cells in inoculated sampe need time to sense and adjust to environemnt
- lag will be diff depending on the state on the inoculum
- in thi time just getting used to environment, might need time to repair
* can use spectrophotonomer to see if getting more cloudy (bateria growing)

describe the exponential/ log growth
- growth rate (rate of inc in biomass) is proportional to the population size at ta given time
- such a growth rate = exponential bc generates exponential curve
- if cell divdes by binary fission the number of cells is proportional to 2n
- if gorwing quickly steeper slope





